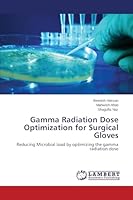
Gamma Radiation Dose Optimization for Surgical Gloves: Reducing Microbial load by optimizing the gamma radiation dose 3659699519 Book Cover

Most Popular Books
- Gamma Radiation Dose Optimization for Surgical Gloves: Reducing Microbial load by optimizing the gamma radiation dose
- Ottimizzazione della dose di radiazioni gamma per guanti chirurgici
- Optymalizacja dawki promieniowania gamma dla rękawiczek chirurgicznych
- Optimierung der Gammastrahlendosis für OP-Handschuhe
- Optimisation de la dose de rayonnement gamma pour les gants chirurgicaux